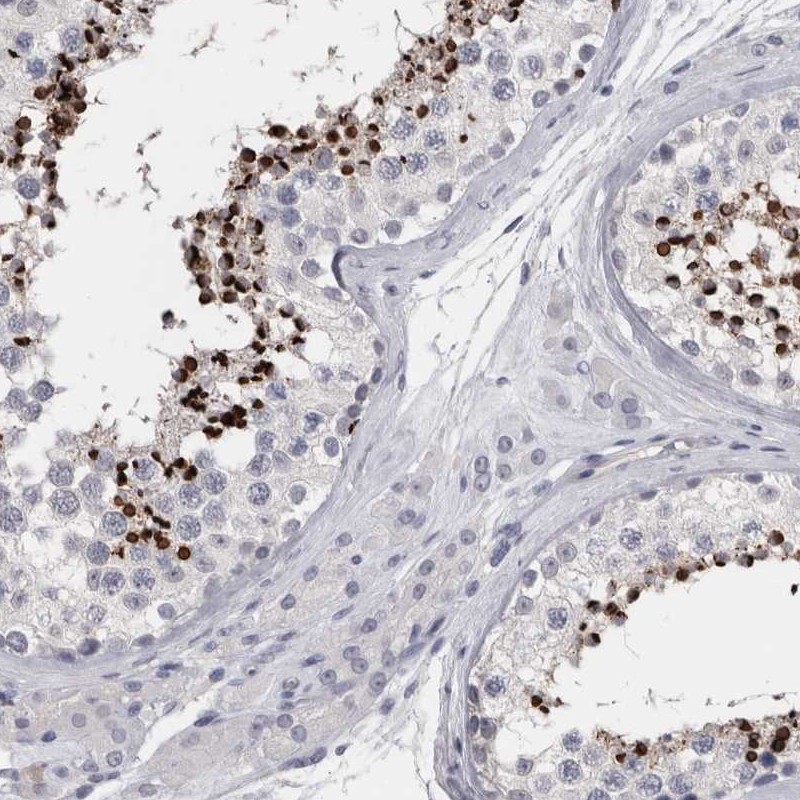

Anti-SPACA1
Catalog Number:
ATA-HPA026744
- Images (12)
| Article Name: | Anti-SPACA1 |
| Biozol Catalog Number: | ATA-HPA026744 |
| Supplier Catalog Number: | HPA026744 |
| Alternative Catalog Number: | ATA-HPA026744-100,ATA-HPA026744-25 |
| Manufacturer: | Atlas Antibodies |
| Host: | Rabbit |
| Category: | Sonstiges |
| Application: | IHC, WB |
| Species Reactivity: | Human |
| Immunogen: | Recombinant Protein Epitope Signature Tag (PrEST) antigen sequence |
| Conjugation: | Unconjugated |
| Alternative Names: | SAMP32 |
| sperm acrosome associated 1 |
| Anti-SPACA1 |
| Clonality: | Polyclonal |
| Concentration: | 0.1 mg/ml |
| Isotype: | IgG |
| NCBI: | 81833 |
| UniProt: | Q9HBV2 |
| Buffer: | 40% glycerol and PBS (pH 7.2). 0.02% sodium azide is added as preservative. |
| Purity: | Affinity purified using the PrEST antigen as affinity ligand |
| Sequence: | REVILTNGCPGGESKCVVRVEECRGPTDCGWGKPISESLESVRLACIHTSPLNRFKYMWKL |
| Storage: | Store at +4°C for short term storage. Long time storage is recommended at -20°C. |
| Target: | SPACA1 |
| Antibody Type: | Monoclonal Antibody |
| Application Dilute: | IHC: 1:200 - 1:500, WB: 0.04-0.4 µg/ml |